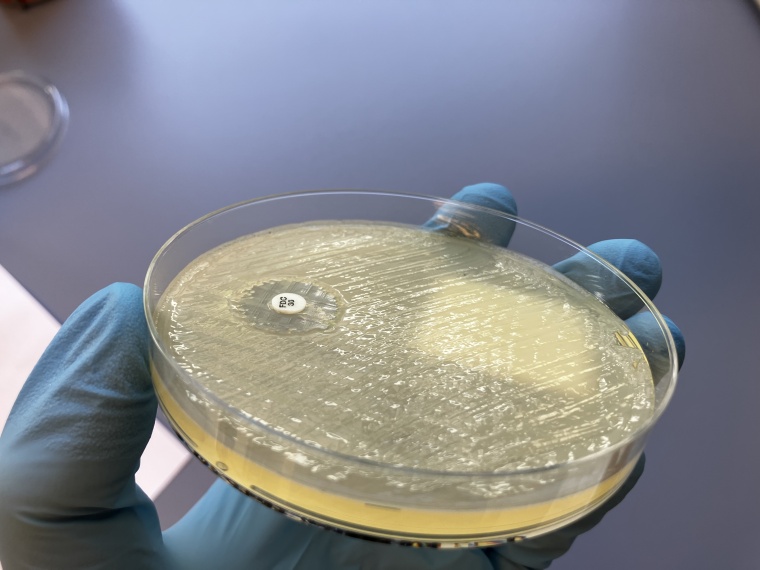
Die isolierten Bakterien wurden mittels Agar-Diffusionstest auf ihre...

Antibiotikaresistente Bakterien in der Ostsee
Ein Forschungsteam des Helmholtz-Instituts für One Health (HIOH) hat die Verbreitung und Eigenschaften von antibiotikaresistenten Bakterien in der Ostsee untersucht.
Die Ergebnisse ihrer Arbeit verdeutlichen, dass resistente Krankheitserreger nicht nur in klinischen, sondern auch in Umweltproben vorkommen.
Zudem unterstreicht die BMBF-geförderte Studie, wie wichtig eine integrierte Strategie zur Bekämpfung von Antibiotikaresistenzen ist, die Umwelt- und Gesundheitsschutz gleichermaßen berücksichtigt. Die Ergebnisse wurden kürzlich im Fachjournal npj Clean Water veröffentlicht.
An dem Projekt waren Forschende des Helmholtz-Instituts für One Health (HIOH), der Universitätsmedizin Greifswald, des Friedrich-Loeffler-Instituts (FLI) sowie der Universität Greifswald beteiligt. Ein Jahr lang nahmen sie mehr als 120 Wasserproben an verschiedenen Standorten in Greifswald und Umgebung: unter anderem in einem Badebereich, in der Nähe von Kläranlagen sowie in einem Schutzgebiet auf der Insel Riems. Ziel war es, das Vorkommen von antibiotikaresistenten Bakterien und die Konzentration von Antibiotikarückständen im Oberflächenwasser zu analysieren.
„Unsere Ergebnisse zeigen, dass einige der isolierten Bakterien als Hochrisikostämme gelten und eine signifikante Resistenz gegen wichtige Antibiotika aufweisen“, erklärt Prof. Katharina Schaufler, Co-Leiterin der Studie und Professorin für Epidemiologie und Ökologie Antimikrobieller Resistenz am HIOH und der Unimedizin Greifswald. Insbesondere in den Proben aus Kläranlagen seien höhere Mengen multiresistenter Erreger und Antibiotikarückstände nachgewiesen worden. In den Boddengewässern konnten zwar ebenfalls resistente Erreger isoliert werden, jedoch in weitaus geringerer Anzahl.
Bakterien und Antibiotikarückstände so gering wie möglich halten
Schaufler betont, dass für gesunde Badegäste mit einem normalen Immunsystem in den untersuchten Gewässern kein erhöhtes Risiko bestehe, sich mit resistenten Bakterien zu infizieren – „unsere Studie dient der Aufklärung und soll keine Ängste schüren“.
Die Studie verdeutliche jedoch, wie schwer es für Kläranlagen ist, resistente Bakterien und Medikamentenrückstände vollständig aus dem Wasser zu entfernen. „Es wäre wünschenswert, Abwasserbehandlungsprozesse weiter zu optimieren, um die Belastung durch resistente Bakterien und Antibiotikarückstände so gering wie möglich zu halten“, so Schaufler. Gleichzeitig sollte der Einsatz von Antibiotika und antimikrobiellen Medikamenten in Medizin und Landwirtschaft gezielter reguliert werden. Denn der Einfluss durch den Menschen spiele bei der Verbreitung resistenter Erreger eine wesentliche Rolle.
„Das Projekt zeigt, wie eng die Gesundheit von Menschen und Tieren in einer gemeinsamen Umwelt zusammenhängen“, betont Prof. Karlhans Endlich, Wissenschaftlicher Vorstand der Unimedizin Greifswald. Es sei wichtig, grundlegende Mechanismen und die Übertragung von Infektionskrankheiten zu verstehen – auch jenseits des Krankenhauses. „Die Untersuchungsergebnisse, die kürzlich im Fachjournal npj Clean Water veröffentlicht wurden, liefern eine wichtige Grundlage für die Entwicklung alternativer Strategien zur Bekämpfung antibiotikaresistenter Bakterien, den Verursachern der sogenannten stillen Pandemie.“
Katharina Schaufler ergänzt, welche Fragestellungen sich an dieser Studie anschließen lassen: „Wie sieht die Situation entlang der Ostseeküste in anderen Ländern aus? Welche Rolle spielen Wasservögel bei der Verbreitung resistenter Bakterien? Und wie lassen sich diese Erkenntnisse in präventive Maßnahmen und alternative Therapieansätze umsetzen? All das sind Fragen, welche künftige Forschungsarbeiten prägen und zur Entwicklung alternativer Strategien im Kampf gegen antibiotikaresistente Bakterien beitragen könnten.“










